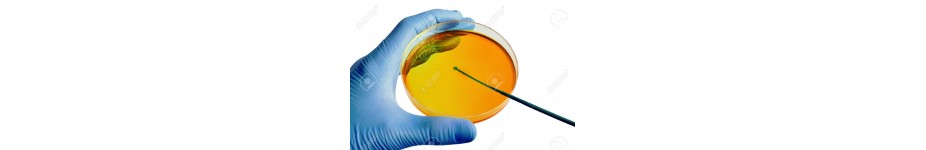

Ci scusiamo per l'inconveniente.
Cerca di nuovo quello che stai cercando
La batteriologia è la branca della microbiologia che studia i batteri, concentrandosi su tutti gli aspetti della loro vita, come la morfologia, la fisiologia, la genetica e la classificazione. È fondamentale in ambito clinico per la diagnosi, il trattamento e la prevenzione delle infezioni batteriche, determinando la sensibilità dei patogeni agli antibiotici.
Cerca di nuovo quello che stai cercando